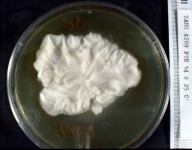

<< back to search
IMAGES:


Search Details
add to cart
| UAMH Number: | 4269 |
|---|---|
| Species Name: | Aspergillus fumigatus |
| Type: | |
| Synonyms: | Aspergillus anomalus / Aspergillus arvii / Aspergillus bronchialis / Aspergillus cellulosae / Aspergillus fumigatus var. acolumnaris / Aspergillus fumigatus var. albus / Aspergillus fumigatus var. cellulosae / Aspergillus fumigatus var. coeruleus / Aspergillus fumigatus var. ellipticus / Aspergillus fumigatus var. fumigatus / Aspergillus fumigatus var. griseibrunneus / Aspergillus fumigatus var. helvolus / Aspergillus fumigatus var. lunzinense / Aspergillus fumigatus var. minimus / Aspergillus neoellipticus / Aspergillus phialiseptatus / Aspergillus phialiseptus / Aspergillus pidoplichknovii / Aspergillus septatus |
| Taxonomy: | FUNGI Ascomycota, Eurotiomycetes, Eurotiales, Aspergillaceae |
| Strain History: | |
| Substrate: | atypical, white, non-sporulating colony from sputum, male 68 yr | Location: | CANADA Alberta, Edmonton, Aberhart Hospital (GEO: 53.518,-113.527) |
| Isolator: | L. Sigler |
| Isolation Date: | 1980-01-29 |
| Date Received: | 1982-08-03 |
| Characters: | HUMAN/ ANIMAL PATHOGEN atypical isolate - Sigler & Carmichael, ASM Abstracts Ann. Mtg. 1981:320 // PIGMENT purple - // THERMOTOLERANT opt. 37-45C, NG @ 55C - (Click for publications citing UAMH 4269) |
| Compounds: | |
| Cross Reference: | UAMH 4270 // UAMH 4271 // UAMH 4275 // UAMH 4279 // UAMH 5878 |
| Collections: | DRIED HERBARIUM MATERIAL ONLY |
| Pathogenic Potential: | N/A |
| Biosafety Risk Group: | Unregulated dead material |
| Regulatory Requirements: | N/A |
| MycoBank ID: | 211776 |
IMAGES: